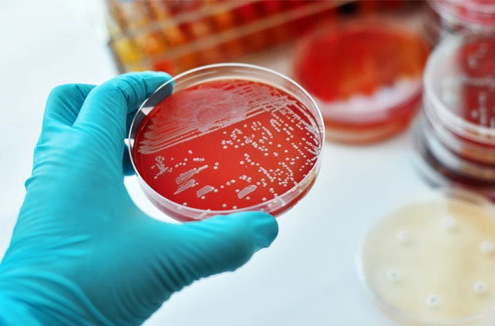

티스토리 뷰
햄버거병 원인 및 증상 치료방법

몇년전 햄버거병이라고 불리며 이슈가 되었던 병입니다. 최근에 급식의 재료가 문제가 되어 또다시 이슈가 되었었는데요. 햄버거병의 정확한 병명은 용혈성 요독 증후군이라고 합니다. 신장에 치명적인 손상을 유발하는 병으로 굉장히 위험한 병으로 알려져 있습니다.
| 햄버거병 발생 원인



햄버거병의 발생 원인은 대장균에 감염되면 발생되는데 고기 덜익었거나 상했을때, 그리고 우유같은 유제품의 살균이 충분히 되지 않은 상태에서 섭취할 경우 발병하게 됩니다.



햄버거 패티는 간 고기를 이용하여 만들었기 때문에 충분히 익지 않은 패티를 먹었을 경우 감염될 위험이 높은데 이런 이유 때문에 햄버거병이라고 불리고 있습니다.
이외에 항암치료 및 후천성 면역결핍증도 햄버거병의 원인이 될 수 있다고 합니다.
| 햄버거병 증상

햄버거병에 걸리면 혈압이 높아지거나 몸이 붓기도하며 경련 및 혼수 상태의 신경계 증상이 나타날 수 있습니다. 그리고 설사 혹은 혈변을 볼 수 있고 고열, 복통, 구토 등 장염 증상을 보이기도 합니다. 그외 빈혈 증상을 보이며 소변량이 감소한다면 햄버거병 즉 용혈성 요독 증후근을 의심해 봐야 합니다.
| 햄버거병 치료 방법



햄버거병은 신부전으로 이어지기 때문에 수분, 전해질 이상 수준을 교정해야하며, 혈압을 조절해야 합니다. 필요에 따라 투석을 해야 할 수도 있습니다. 항생제를 사용하여 치료하기도 하는데 항생제 투여량이 많으면 증상이 더 악화될 수 있기 때문에 조심해야 합니다. 그리고 빈혈을 동반하기 때문에 빈혈 증상이 심하다면 수혈을 받기도 합니다.



햄버거병에 걸릴 경우 신장의 기능을 많이 상실하기에 완치는 어려운것으로 알려져 있습니다. 안타깝게도 이번에 발생된 유치원의 아이들은 일부 장애 판정을 받기도 했습니다. 이런 병은 발생하지 않았으면 하는 마음입니다. 햄버거병에 걸리지 않도록 주의하시기 바랍니다.